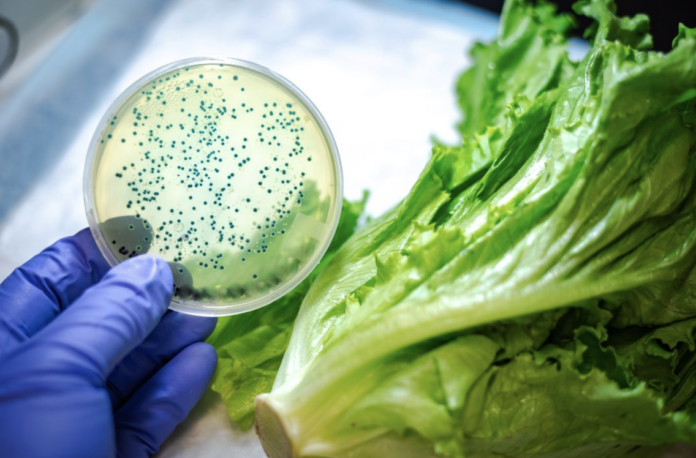

La Agencia Canadiense de Inspección de Alimentos (CFIA) emitió esta semana una serie de retiros voluntarios que afectan a decenas de productos vendidos en supermercados de todo el país. El motivo: posible contaminación con Listeria monocytogenes, una bacteria capaz de causar una infección grave conocida como listeriosis. Aunque hasta el momento no se han reportado casos de enfermedad vinculados a este retiro, las autoridades piden actuar con precaución.
Contenido
Qué productos están afectados
El retiro cubre tres categorías principales de alimentos. En primer lugar, quesos de diversas marcas comercializadas a nivel nacional, entre ellos la mezcla de tres quesos para nachos de la marca Bothwell (en presentaciones de 400 gramos y un kilogramo), el queso procesado rallado estilo cheddar de Goldstream y el queso Asiago rallado de Paradise Island. En segundo lugar, ensaladas de la marca Co-Op con aderezo de ajo cremoso y espinaca, vendidas en Alberta, Columbia Británica, Manitoba, Territorios del Noroeste y Saskatchewan, con fechas de consumo preferente entre el 24 de marzo y el 4 de abril. Por último, algunos ingredientes de queso incluidos en ciertos kits de cocina de HelloFresh, comercializados en todo Canadá, cuyo retiro se amplió respecto a una alerta previa emitida la semana anterior.
Para verificar si un producto específico está incluido en el retiro, es posible consultar el sitio oficial de la CFIA en recalls-rappels.canada.ca, donde se actualiza continuamente la lista completa con números de lote, fechas y regiones afectadas.
Por qué preocupa la listeria
La listeria es una bacteria que puede sobrevivir incluso en refrigeración, lo que la distingue de muchos otros patógenos alimentarios. Una característica especialmente importante es que un producto contaminado no siempre presenta cambios visibles en su aspecto, olor o textura: puede parecer en perfecto estado y aun así representar un riesgo.
Los síntomas de la listeriosis incluyen fiebre persistente, náuseas, vómitos y dolores musculares. En la mayoría de los adultos sanos, la infección se resuelve sin complicaciones graves. Sin embargo, el riesgo es significativamente mayor en ciertos grupos: mujeres embarazadas, personas mayores de 60 años, bebés y quienes tienen el sistema inmunológico debilitado por enfermedades crónicas o tratamientos médicos. En estos casos, la infección puede extenderse al sistema nervioso y provocar complicaciones severas.
“La listeria puede causar una infección grave en personas vulnerables”, señaló la CFIA en su comunicado oficial. “Se recomienda a quienes hayan comprado estos productos que los revisen y, si están incluidos en el retiro, que los desechen o los devuelvan al establecimiento de compra.”
Qué se debe hacer si se tiene alguno de estos productos
La recomendación de la CFIA es clara: no consumir los productos afectados. Lo indicado es desecharlos de forma segura o devolverlos al lugar de compra para obtener un reembolso. En caso de haberlos consumido recientemente y presentar síntomas como fiebre, náuseas o malestar general, se recomienda contactar a un médico y mencionar el posible consumo de productos bajo alerta de listeria. Quienes tengan dudas sobre si un alimento está incluido en el retiro pueden verificarlo directamente en el sitio web de recalls-rappels.canada.ca o llamar a la línea de información alimentaria de la CFIA.
Este tipo de retiro masivo no es inusual en Canadá: la CFIA monitorea de forma continua los alimentos en circulación y actúa con rapidez ante cualquier riesgo detectado. Lo más importante en estos casos es revisar los productos en casa y no esperar a que aparezcan síntomas.
Redacción de: Mauricio Navas Talero LJI Reporter
Fuentes: CBC News (4 de abril de 2026), Canadian Food Inspection Agency – recalls-rappels.canada.ca, Global News (4 de abril de 2026), CP24 (4 de abril de 2026).